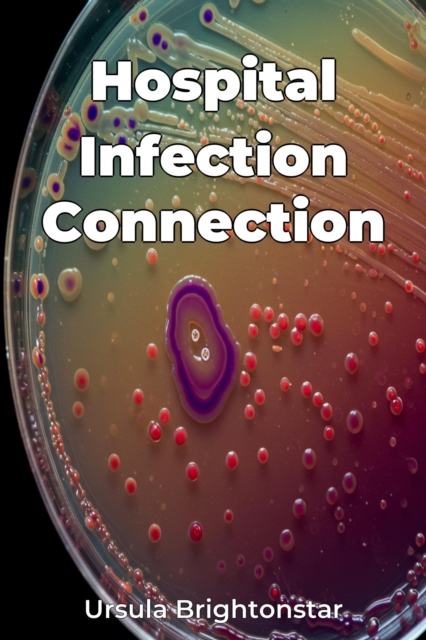
Hospital Infection Connection

Hospital Infection Connection
Hospital Infection Connection explores the surprising link between antibacterial detergents in hospitals and the rise of antibiotic-resistant bacteria, or "superbugs". It questions whether the prevalent use of these detergents, intended to combat infection, may inadvertently be fueling the problem. The book provides a comprehensive overview of how bacteria develop resistance, examining the impact ...
Hospital Infection Connection explores the surprising link between antibacterial detergents in hospitals and the rise of antibiotic-resistant bacteria, or "superbugs". It questions whether the prevalent use of these detergents, intended to combat infection, may inadvertently be fueling the problem. The book provides a comprehensive overview of how bacteria develop resistance, examining the impact ...
